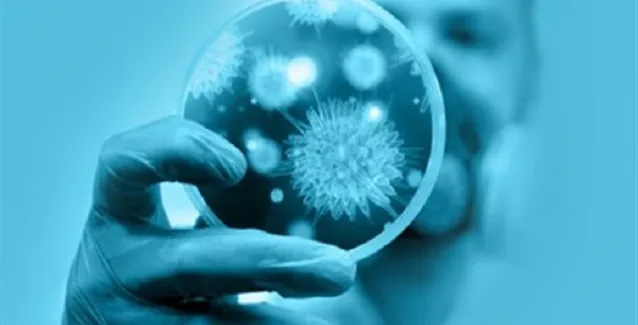
Πρωτοποριακή θεραπεία για τα αυτοάνοσα νοσήματα

Πρωτοποριακή θεραπεία για τα αυτοάνοσα νοσήματα
Πίνακας περιεχομένων
Επιστήμονες στις ΗΠΑ –μεταξύ των οποίων ένας ελληνικής καταγωγής– τροποποίησαν γενετικά στο εργαστήριό τους τα ζωτικά Τ-κύτταρα του ανοσοποιητικού συστήματος, έτσι ώστε αυτά, όταν επανεισάγονται στο σώμα, να καταστρέφουν επιλεκτικά μόνο τα κύτταρα που έχουν στραφεί κατά του οργανισμού. Αντίθετα, αφήνουν σώα τα υγιή κύτταρα του ανοσοποιητικού συστήματος, που συνεχίζουν να προστατεύουν το σώμα. Η […]
Επιστήμονες στις ΗΠΑ –μεταξύ των οποίων ένας ελληνικής καταγωγής– τροποποίησαν γενετικά στο εργαστήριό τους τα ζωτικά Τ-κύτταρα του ανοσοποιητικού συστήματος, έτσι ώστε αυτά, όταν επανεισάγονται στο σώμα, να καταστρέφουν επιλεκτικά μόνο τα κύτταρα που έχουν στραφεί κατά του οργανισμού.
Αντίθετα, αφήνουν σώα τα υγιή κύτταρα του ανοσοποιητικού συστήματος, που συνεχίζουν να προστατεύουν το σώμα.
Η νέα τεχνική, η οποία δοκιμάσθηκε με επιτυχία σε πειραματόζωα (ποντίκια), ουσιαστικά «πυροδοτεί» έναν εμφύλιο πόλεμο στο ανοσοποιητικό σύστημα –αλλά με καλό σκοπό. Η μέθοδος αποτελεί ένα ουσιαστικό βήμα για την αντιμετώπιση των αυτοάνοσων παθήσεων με τρόπο που να μην καταστρέφει αδιακρίτως τα κύτταρα του ανοσοποιητικού συστήματος, αλλά μόνο όσα δεν επιτελούν πλέον τον αμυντικό ρόλο τους. Κάτι τέτοιο έως τώρα δεν ήταν εφικτό.
Ορισμένες αυτοάνοσες παθήσεις εκδηλώνονται όταν τα Β-λεμφοκύτταρα, τα οποία παράγουν αντισώματα, λανθασμένα «βλέπουν» τον ιστό του ασθενούς ως ξένο σώμα, ωθώντας όλο το ανοσοποιητικό σύστημα να στραφεί εναντίον του. Σήμερα, σε τέτοιες περιπτώσεις χορηγούνται θεραπείες γενικευμένης ανοσοκαταστολής (με φάρμακα όπως η ριτουξιμάμπη και η πρεδνιζόνη), οι οποίες συχνά αφήνουν τον ασθενή πιο ευάλωτο σε πιθανώς μοιραίες λοιμώξεις ή σε καρκίνους. Επιπλέον, αρκετοί ασθενείς υποτροπιάζουν μετά τη θεραπεία.
Οι επιστήμονες από τις ΗΠΑ, την Ιταλία και την Ελβετία, με επικεφαλής τον Κριστόφ Έλεμπρεχτ του Πανεπιστημίου της Πενσιλβάνια, έκαναν τη σχετική δημοσίευση στο περιοδικό Science. Στη μελέτη συμμετείχε και ο διακεκριμένος ελληνικής καταγωγής καθηγητής δερματολογίας Γιώργος Κωτσαρέλης της Ιατρικής Σχολής του ίδιου αμερικανικού πανεπιστημίου.
Εμπνεόμενοι από μια παρόμοια αντικαρκινική τεχνική, η οποία τελευταία είχε θετικά αποτελέσματα στη θεραπεία της λευχαιμίας και του λεμφώματος, οι ερευνητές κατάφεραν να δημιουργήσουν Τ-κύτταρα που στοχεύουν μόνο στα «ανεξέλεγκτα» Β-λεμφοκύτταρα. Στη συνέχεια, έδειξαν ότι είναι δυνατό να αντιμετωπίσουν στα ποντίκια μια σπάνια αυτοάνοση δερματολογική πάθηση, την πέμφιγα, που μπορεί να αποβεί ακόμη και απειλητική για τη ζωή.
Θα ακολουθήσουν δοκιμές σε σκύλους, οι οποίες, αν είναι επιτυχείς, θα ανοίξουν το δρόμο για κλινικές δοκιμές σε ανθρώπους, κατ’ αρχήν με τη δερματολογική πάθηση της πέμφιγας, όμως μια τέτοια θεραπεία αναμένεται να είναι πολύ ακριβή.
Οι επιστήμονες αισιοδοξούν πάντως ότι η νέα μέθοδος μπορεί να εφαρμοσθεί και σε άλλες αυτοάνοσες παθήσεις, καθώς και στην αποφυγή της απόρριψης μοσχευμάτων από τον οργανισμό. Η χρησιμότητά της θα αφορά κυρίως όσες αυτοάνοσες παθήσεις προκαλούνται από κάποιο προφανές αντίσωμα, καθώς σε πολλές κοινές παθήσεις (συστηματικός ερυθηματώδης λύκος, πολλαπλή σκλήρυνση, διαβήτης τύπου 1 κ.α.) οι αιτίες είναι συνήθως πολλαπλές και πολύπλοκες.
Ακολουθείστε το iPaidia στο Google News
Tελευταίες Ειδήσεις για την Παιδεία και την εργασία στο iPaidia.gr





